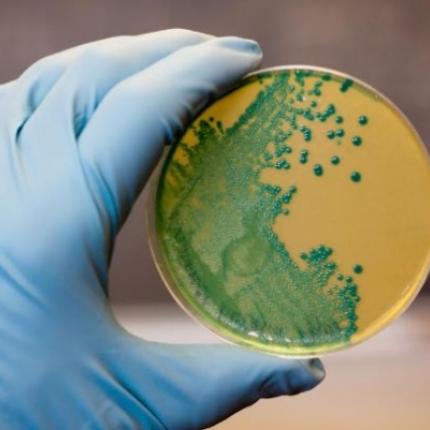
3d9a979b1c7ae6adda1ab5edd6c87151_l.jpg

Τα περιστατικά μόλυνσης από λιστέρια (Listeria monocytogenes) παρουσιάζουν αύξηση σε δύο
ΠΕΡΙΣΤΑΤΙΚΑ ΜΟΛΥΝΣΗΣ
Ράδιο Κρήτη © | 2013 -2026
ekriti.gr
Όροι Χρήσης
|
Ταυτότητα
Designed by
Cloudevo, developed by
Pixelthis